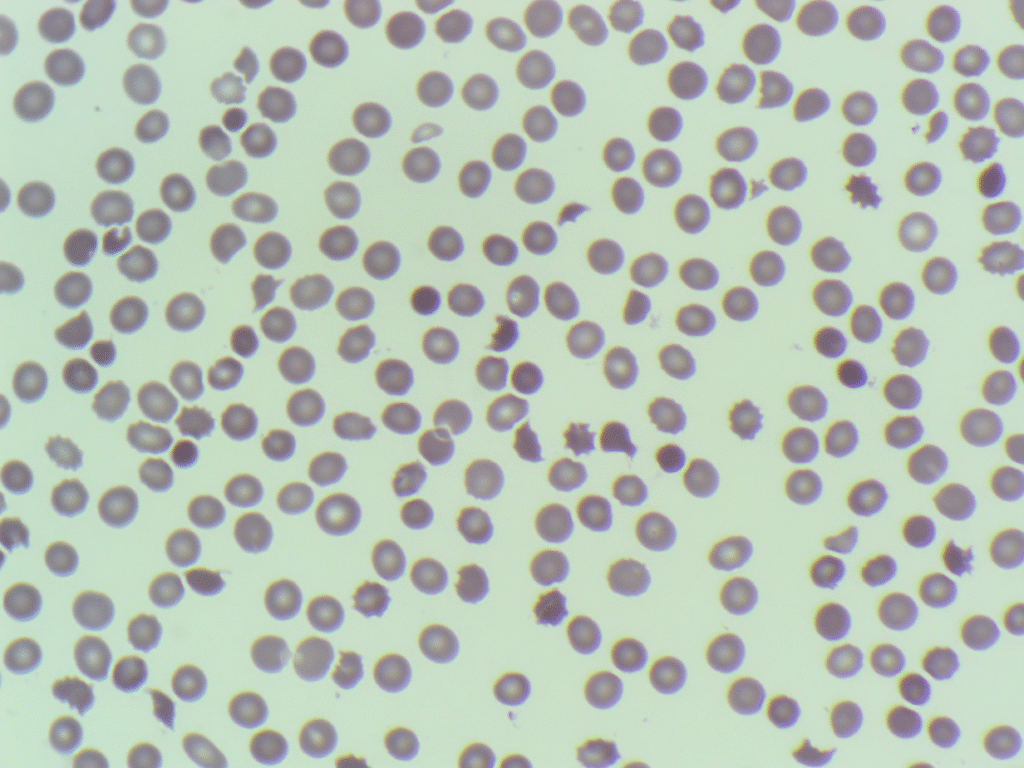
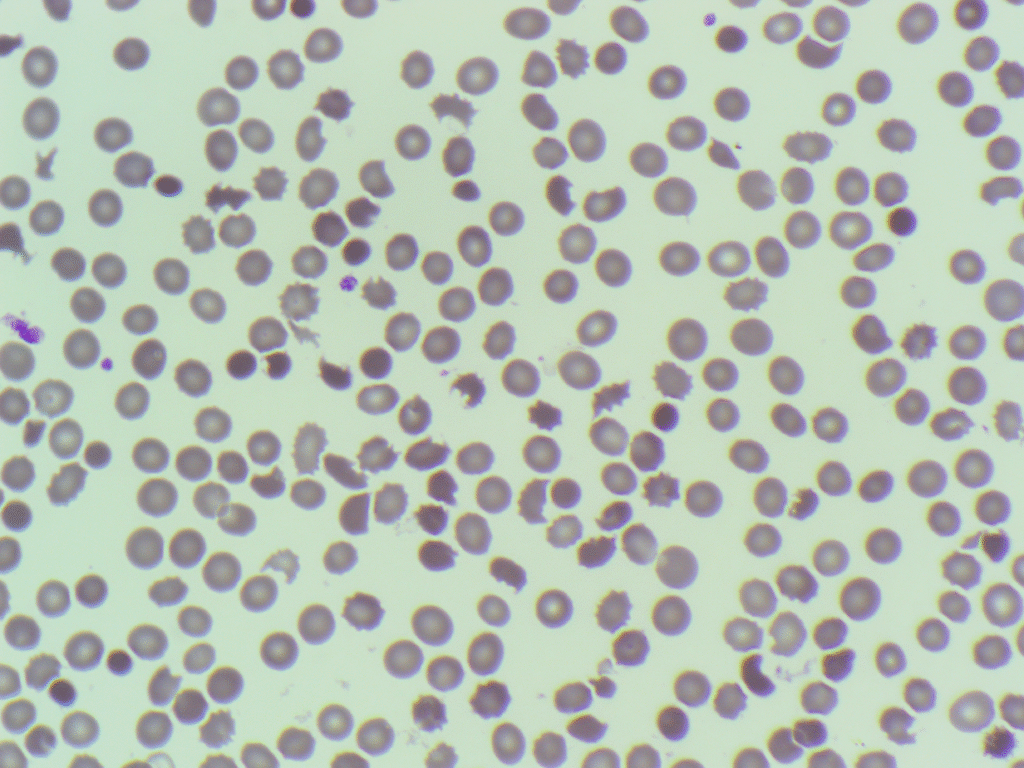
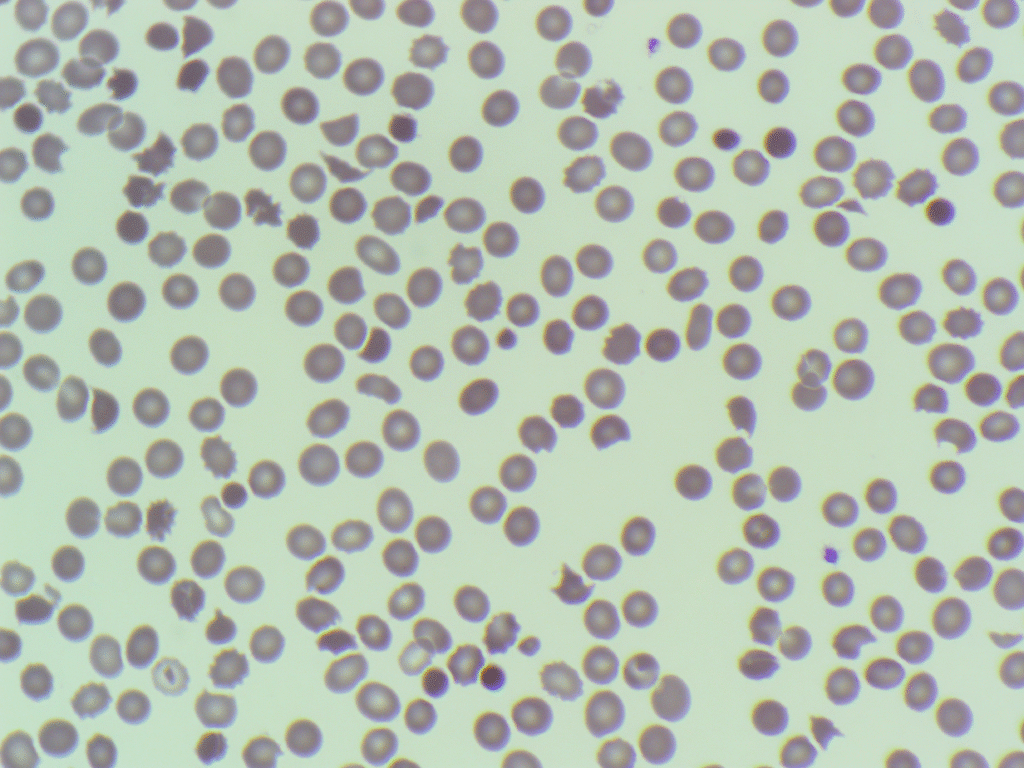
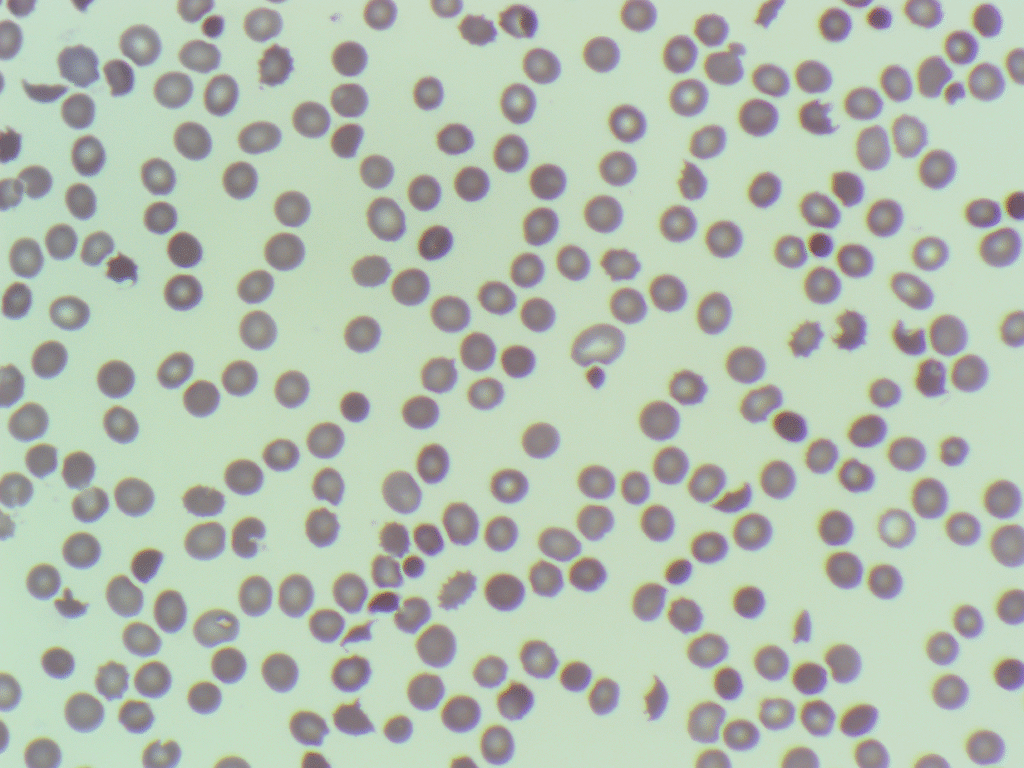
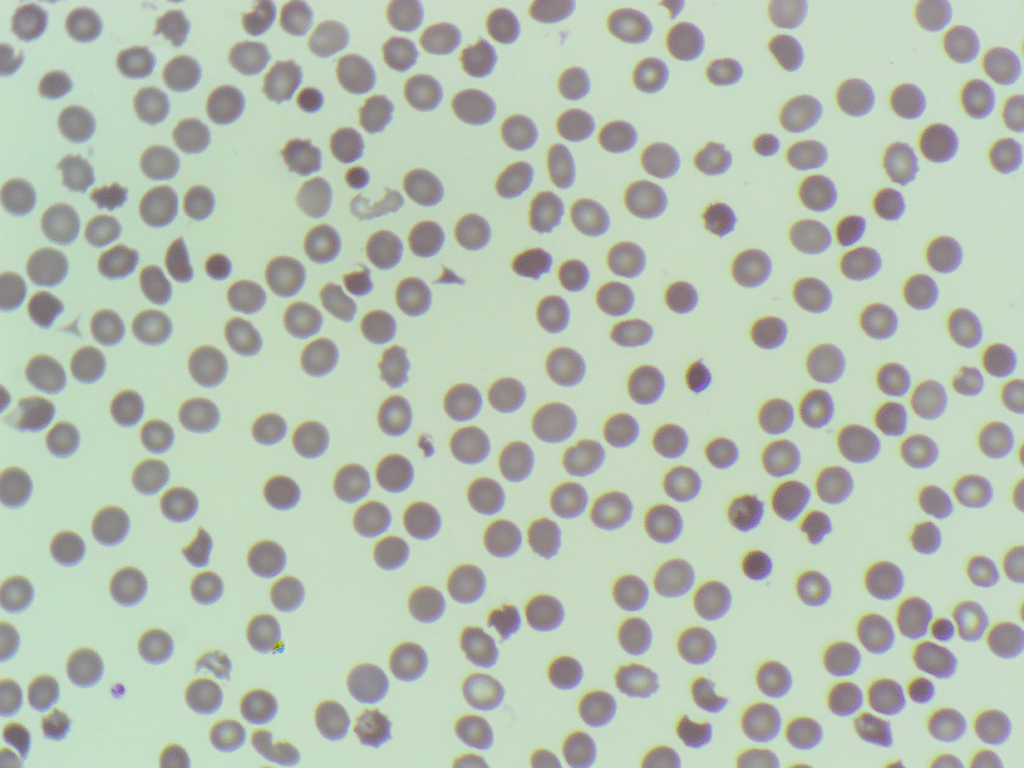
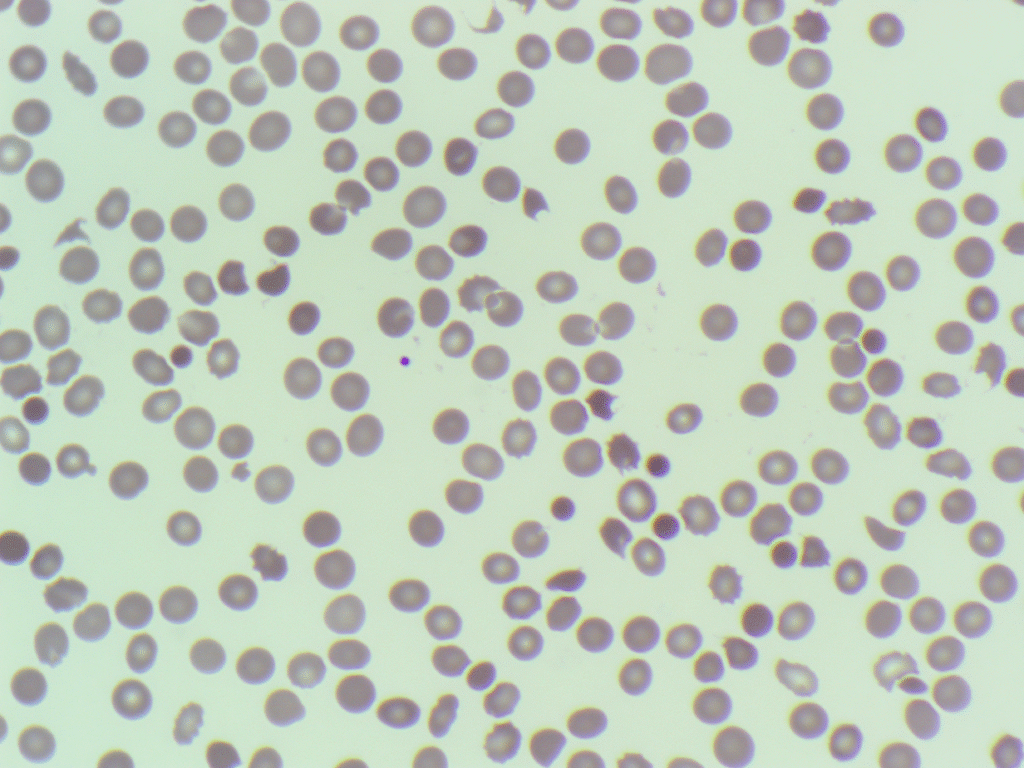
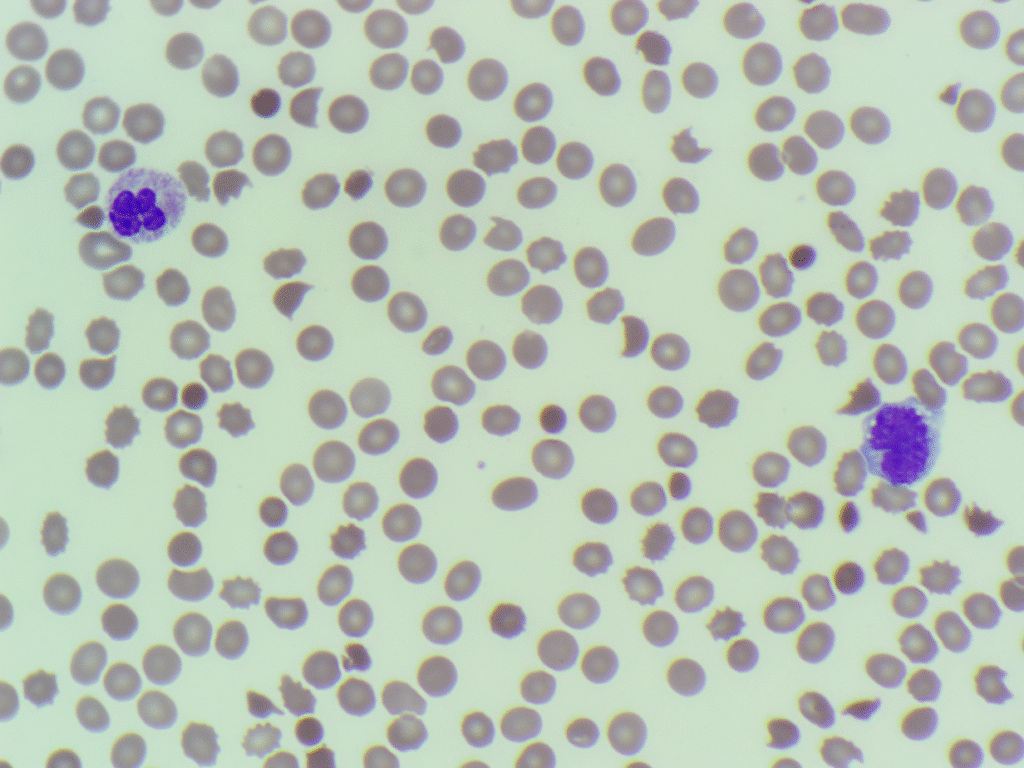

This week’s Morphology Monday case comes from a 35 year old male who presented with:
- Fatigue and pallor
- Easy bruising
- Reduced urine output
- Mild abdominal pain following a recent gastrointestinal illness
The full blood count results showed the following:
- Hb: 113 g/L
- WBC: 5.46 ×10⁹/L
- PLT: 16 ×10⁹/L
Due to the severely low PLT results a blood film was made. The images are below:

Biochemistry results:
- Creatinine: 257 μmol/L
- Bilirubin: 49 μmol/L
- ALT: 77 U/L
- Calcium: 1.84 mmol/L
- Phosphate: 0.4 mmol/L
Other results:
- ADAMTS13 activity: 64.7 IU/dL (within normal range)
Given the clinical presentation, the laboratory investigation results and the blood film images, what do you think is wrong with the patient?
3 Comments
Severe hemolysis and fragmentocytosis favor microangiopathic fragmentation syndromes like HUS and ITP. TTP ruled out due to regular ADAMTS13 activity.
Perfect!